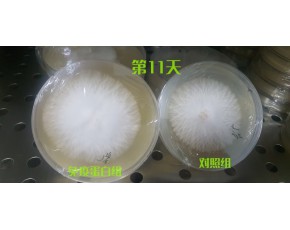
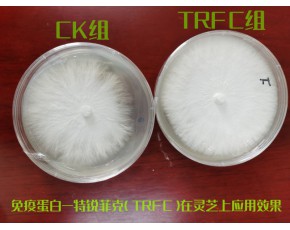
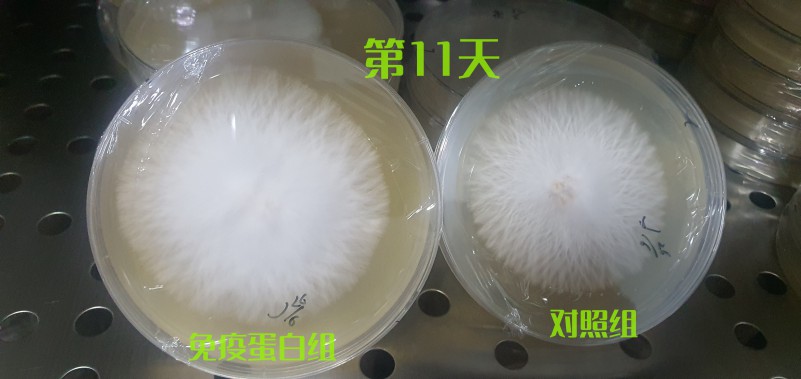
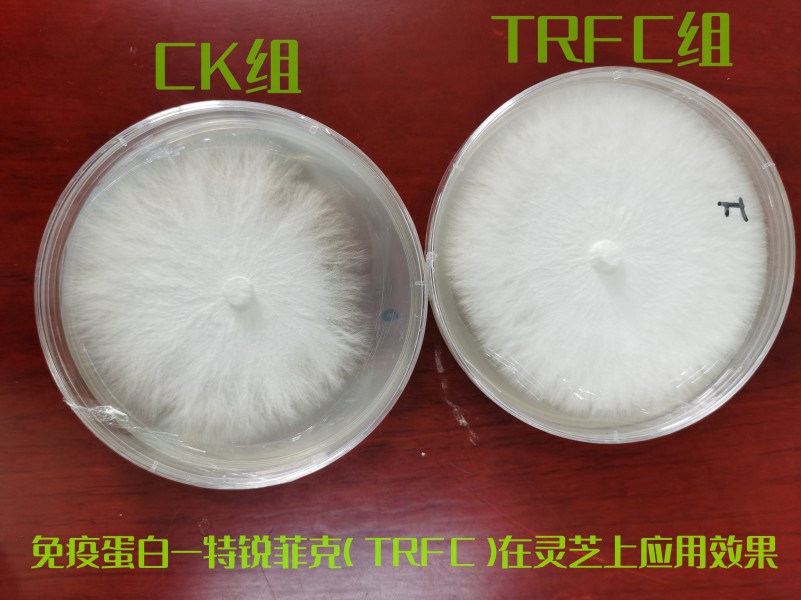

蛋白胨替代型
產品說明:選用優(yōu)質豆粕、麩皮�����、玉米粉��、礦物質等為主要原料���,微生物發(fā)酵技術制取,富含食用菌生長所需的蛋白質�、肽、氨基酸����、糖等多種活性物質����。
產品特性: 1�����、提升菌絲體胞外蛋白產率與胞外酶活性�,增加菌絲體生物量。2����、富含免疫因子,增強菌絲體免疫力與抗逆性����,提高菌絲體抗病性。
適用范圍:本品涵蓋但不限于蛋白胨功效���,可完全替代培養(yǎng)基中的蛋白胨��,適用于食用菌菌種培養(yǎng)基添加應用�����。
使用方法:每升液態(tài)培養(yǎng)基添加本品3克(等同于蛋白胨1克~2克)~4克(等同于蛋白胨2~3克)�。使用時按比例取相應量本品,加入少量清水溶解后添加到培養(yǎng)基攪拌均勻滅菌備用���。
注意事項: 1���、本品對菌種起增效作用,請按照規(guī)定用量添加�。2、產品有效期為24個月��,生產日期見包裝���。
主要技術指標:有機質≥40%��,N+ P2O5+K2O≥5%�,粗蛋白≥20%
應用實例: